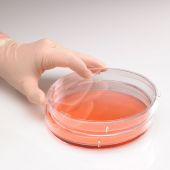
CytoOne 150 x 20 mm Tissue Culture Dish, Sterile, 60pcs/unit

ThawSTAR CB Barrier Bags, 1000 ml, 25 per pack

ERP
BIL-AST-91000
The Largest 100% Canadian Owned and Operated Lab Equipment Distributor and Service Provider.
Free Technical Support
In-depth and personal over-the-phone support at no cost.
Quality Parts & Accessories
Mandel uses manufacturer-specified parts for all repairs and maintenance.